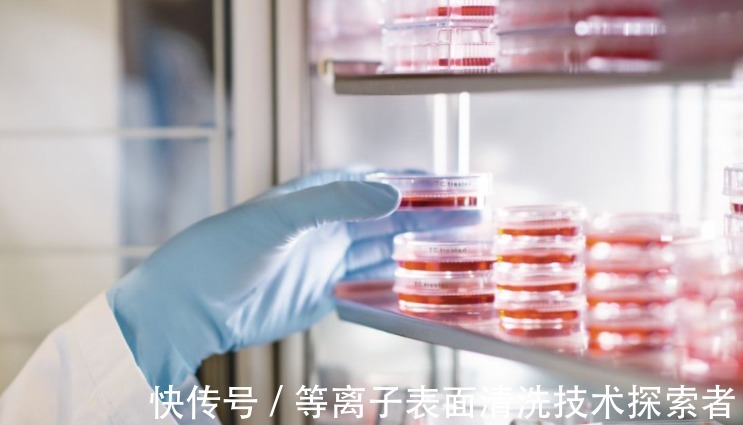

- · 微处理机版面费是多少[08/04]
- · 《微处理机》投稿方式[08/04]
- · 《微处理机》期刊栏目设[08/04]
低温等离子表面处理机在聚合物领域应用之下,
作者:网站采编关键词:
摘要:您了解了等离子表面处理机的优点吗?具有哪些新奇之处呢?其实等离子表面处理机不仅仅是效率高,能在短期内完成,而且具有价格低廉:设备简单,替代昂贵的清洗剂,节省不必要
您了解了等离子表面处理机的优点吗?具有哪些新奇之处呢?其实等离子表面处理机不仅仅是效率高,能在短期内完成,而且具有价格低廉:设备简单,替代昂贵的清洗剂,节省不必要的成本;其次处理比较细致,可深入微孔和凹坑内,并完成表面处理,适用范围广,等离子体表面处理机能够实现对大多数固体物质的处理,具有广泛的用途。
下面就给大家科普一下,借助等离子表面处理机可以处理哪些产品?
聚合物.和纺织品半,半导体工业、金属、医疗器械、电子元件和液晶显示器,印刷包装.硅胶制品.精密玻璃.电线电缆.电子数码.汽车制造.医疗生物、纺织工业.复合材料及新能源等几乎所有行业,适用范围非常之广。
下面就为大家分析一下,低温等离子表面处理机在聚合物领域应用之下,会发生什么变化?
1.聚合物表面清洁:等离子可以通过高能电子和离子轰击材料表面,从而机械地去除污物层。
2.高聚物的表面重组:使用等离子消融的惰性气体破坏聚合物表面的化学键,因此在聚合物表面产生自由功能团。高分子表面的自由官能团可形成原始的聚合物结构,也可与位于同一聚合物链上的自由官能团成键,或可与不同聚合物链附近的自由官能团成链。高分子表面重组可以提高表面硬度和化学抗性。
3.聚合物表面改性:当聚合物的总体性能不变时,材料表面的化学性质会发生变化。等离子体消融作用使聚合物表面的化学键断裂,在聚合物表面形成自由基。利用离子气体的化学性质,即表面自由官能团与等离子体内原子或化学基团相结合而形成大分子功能群来代替原来的表面高分子功能群。
总而言之,采用等离子技术,无论在塑料金属或玻璃表面,都能获得较高的表面能量,经过处理后,其表面状况可以完全满足后继涂层.粘接等工艺要求。利用等离子技术对上述产品可以进行等离子清洁,可提高表面的附着力和活性。低温等离子体表面处理技术是一种对环境友好、不需要机械加工、不需要化学试剂修饰的微细表面改性方法,可使材料表面洁净.活化,增强其结合能力或赋予全新的表面性能。
文章来源:《微处理机》 网址: http://www.weichulijizz.cn/zonghexinwen/2021/1126/386.html
上一篇:低温等离子表面处理机在聚合物领域是如何起到
下一篇:生物制品工艺曲线的要求